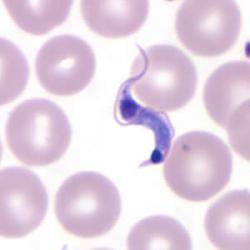
Avatar

🚀 We’re Upgrading the Mothership!
Our site is moving to a shiny new platform.
The engines are warming up, the crew is busy, and it may take a little while ⏳.
Sit tight, we’ll be back better, faster, and cooler than ever. 🌌
The longest running Pinoy-Australian Forum site in the history. We are connecting Pinoys "in" and "to" Australia since 2010! If you want to join in, click one of these buttons!

 lock_code2004
lock_code2004

 TasBurrfoot
TasBurrfoot

 batman
batman
 LokiJr
LokiJr
 danyan2001us
danyan2001us
 Captain_A
Captain_A
Our site is moving to a shiny new platform.
The engines are warming up, the crew is busy, and it may take a little while ⏳.
Sit tight, we’ll be back better, faster, and cooler than ever. 🌌